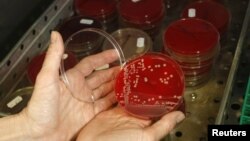
Seorang petugas memperlihatkan bakteri 'superbug' di sebuah laboratorium mikrobiologi di Berlin, Jerman.

Usaha segera yang terfokus untuk menghentikan penyebaran bakteri yang kebal antibiotik dapat menyelamatkan puluhan ribu nyawa dan mencegah ratusan ribu infeksi baru dalam lima tahun mendatang, menurut laporan pemerintah Amerika yang dikeluarkan Selasa (4/8).
Menurut laporan Pusat Pengendalian Penyakit AS (CDC), 37.000 kematian dapat dicegah dan 619.000 infeksi dapat dicegah jika departemen kesehatan dan sarana perawatan kesehatan mendapatkan cara yang dengan cepat mengenali dan menanggulangi wabah bakteri kebal antibiotik.
Bakteri 'superbug' itu telah menyebabkan lebih dari dua juta orang sakit dan 23.000 orang meninggal setiap tahun di Amerika Serikat, menurut laporan CDC. Bakteri ini biasanya muncul ketika antibiotik terlalu banyak digunakan.
Bakteri kebal sering menyebar di rumah sakit, terutama di antara pasien yang imunitasnya lemah.
“Rumah sakit yang bekerja sendiri tidak dapat dengan memadai melindungi pasien mereka,” kata Direktur CDC Tom Frieden. “Puluhan ribu kematian dapat dicegah” dengan koordinasi yang lebih ketat, katanya.
Berdasarkan data penelitian yang tersedia, CDC memperkirakan bahwa koordinasi yang lebih ketat dapat mengurangi infeksi bakteri kebal sampai 80 persen di setiap daerah dalam lima tahun.